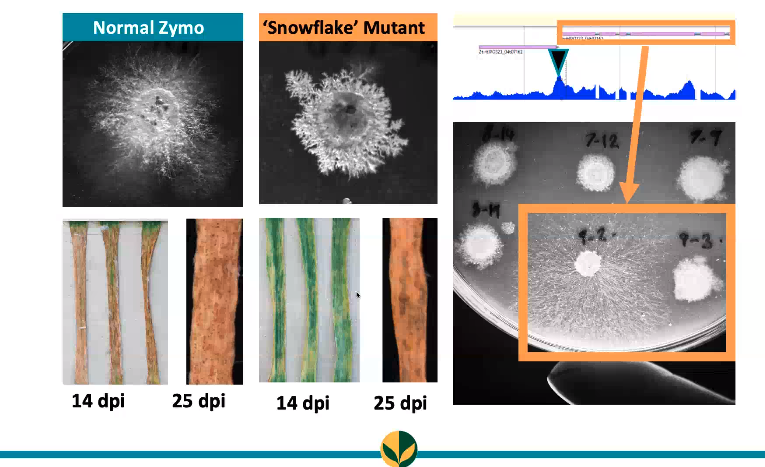
The first speaker is  @StellaRemnant from  @UoNBiosciences, based at  @Rothamsted Her picture featured a snowflake mutant of the plant pathogen, Zymoseptoria   #WomenInScience  #plantsci  #plantpathologist

We have launched our #AgriFoodBecause celebration!!! We will give a bit of an introduction to our group, @SCIupdate and hear stories behind the winner photos! #plantsci
The first speaker is @StellaRemnant from @UoNBiosciences, based at @Rothamsted 


Her picture featured a snowflake mutant of the plant pathogen, Zymoseptoria #WomenInScience #plantsci #plantpathologist
#WomenInScience #plantsci #plantpathologist



Her picture featured a snowflake mutant of the plant pathogen, Zymoseptoria
 #WomenInScience #plantsci #plantpathologist
#WomenInScience #plantsci #plantpathologist
Our second speaker is @JordanCuff (with a fresh haircut)!
He took his ladybird picture in Cardiff as a PhD student at @cardiffuni and @Rothamsted on @SWBio_DTP
He actually worked with spiders and you can read about it on @BritishEcolSoc's blog: https://methodsblog.com/2021/02/10/medi-macronutrient-extraction-and-determination-from-invertebrates/
and you can read about it on @BritishEcolSoc's blog: https://methodsblog.com/2021/02/10/medi-macronutrient-extraction-and-determination-from-invertebrates/
He took his ladybird picture in Cardiff as a PhD student at @cardiffuni and @Rothamsted on @SWBio_DTP

He actually worked with spiders
 and you can read about it on @BritishEcolSoc's blog: https://methodsblog.com/2021/02/10/medi-macronutrient-extraction-and-determination-from-invertebrates/
and you can read about it on @BritishEcolSoc's blog: https://methodsblog.com/2021/02/10/medi-macronutrient-extraction-and-determination-from-invertebrates/
The third speaker is @Johannaastrand1 doing an industrial PhD at @UniofNottingham, talking about a beautiful bouquet of wheat in Cambridgeshire 

There is so much diversity in anther traits between different cultivars - such a beautiful plant!!! #plantsci #WomenInScienceDay


There is so much diversity in anther traits between different cultivars - such a beautiful plant!!! #plantsci #WomenInScienceDay

 Read on Twitter
Read on Twitter